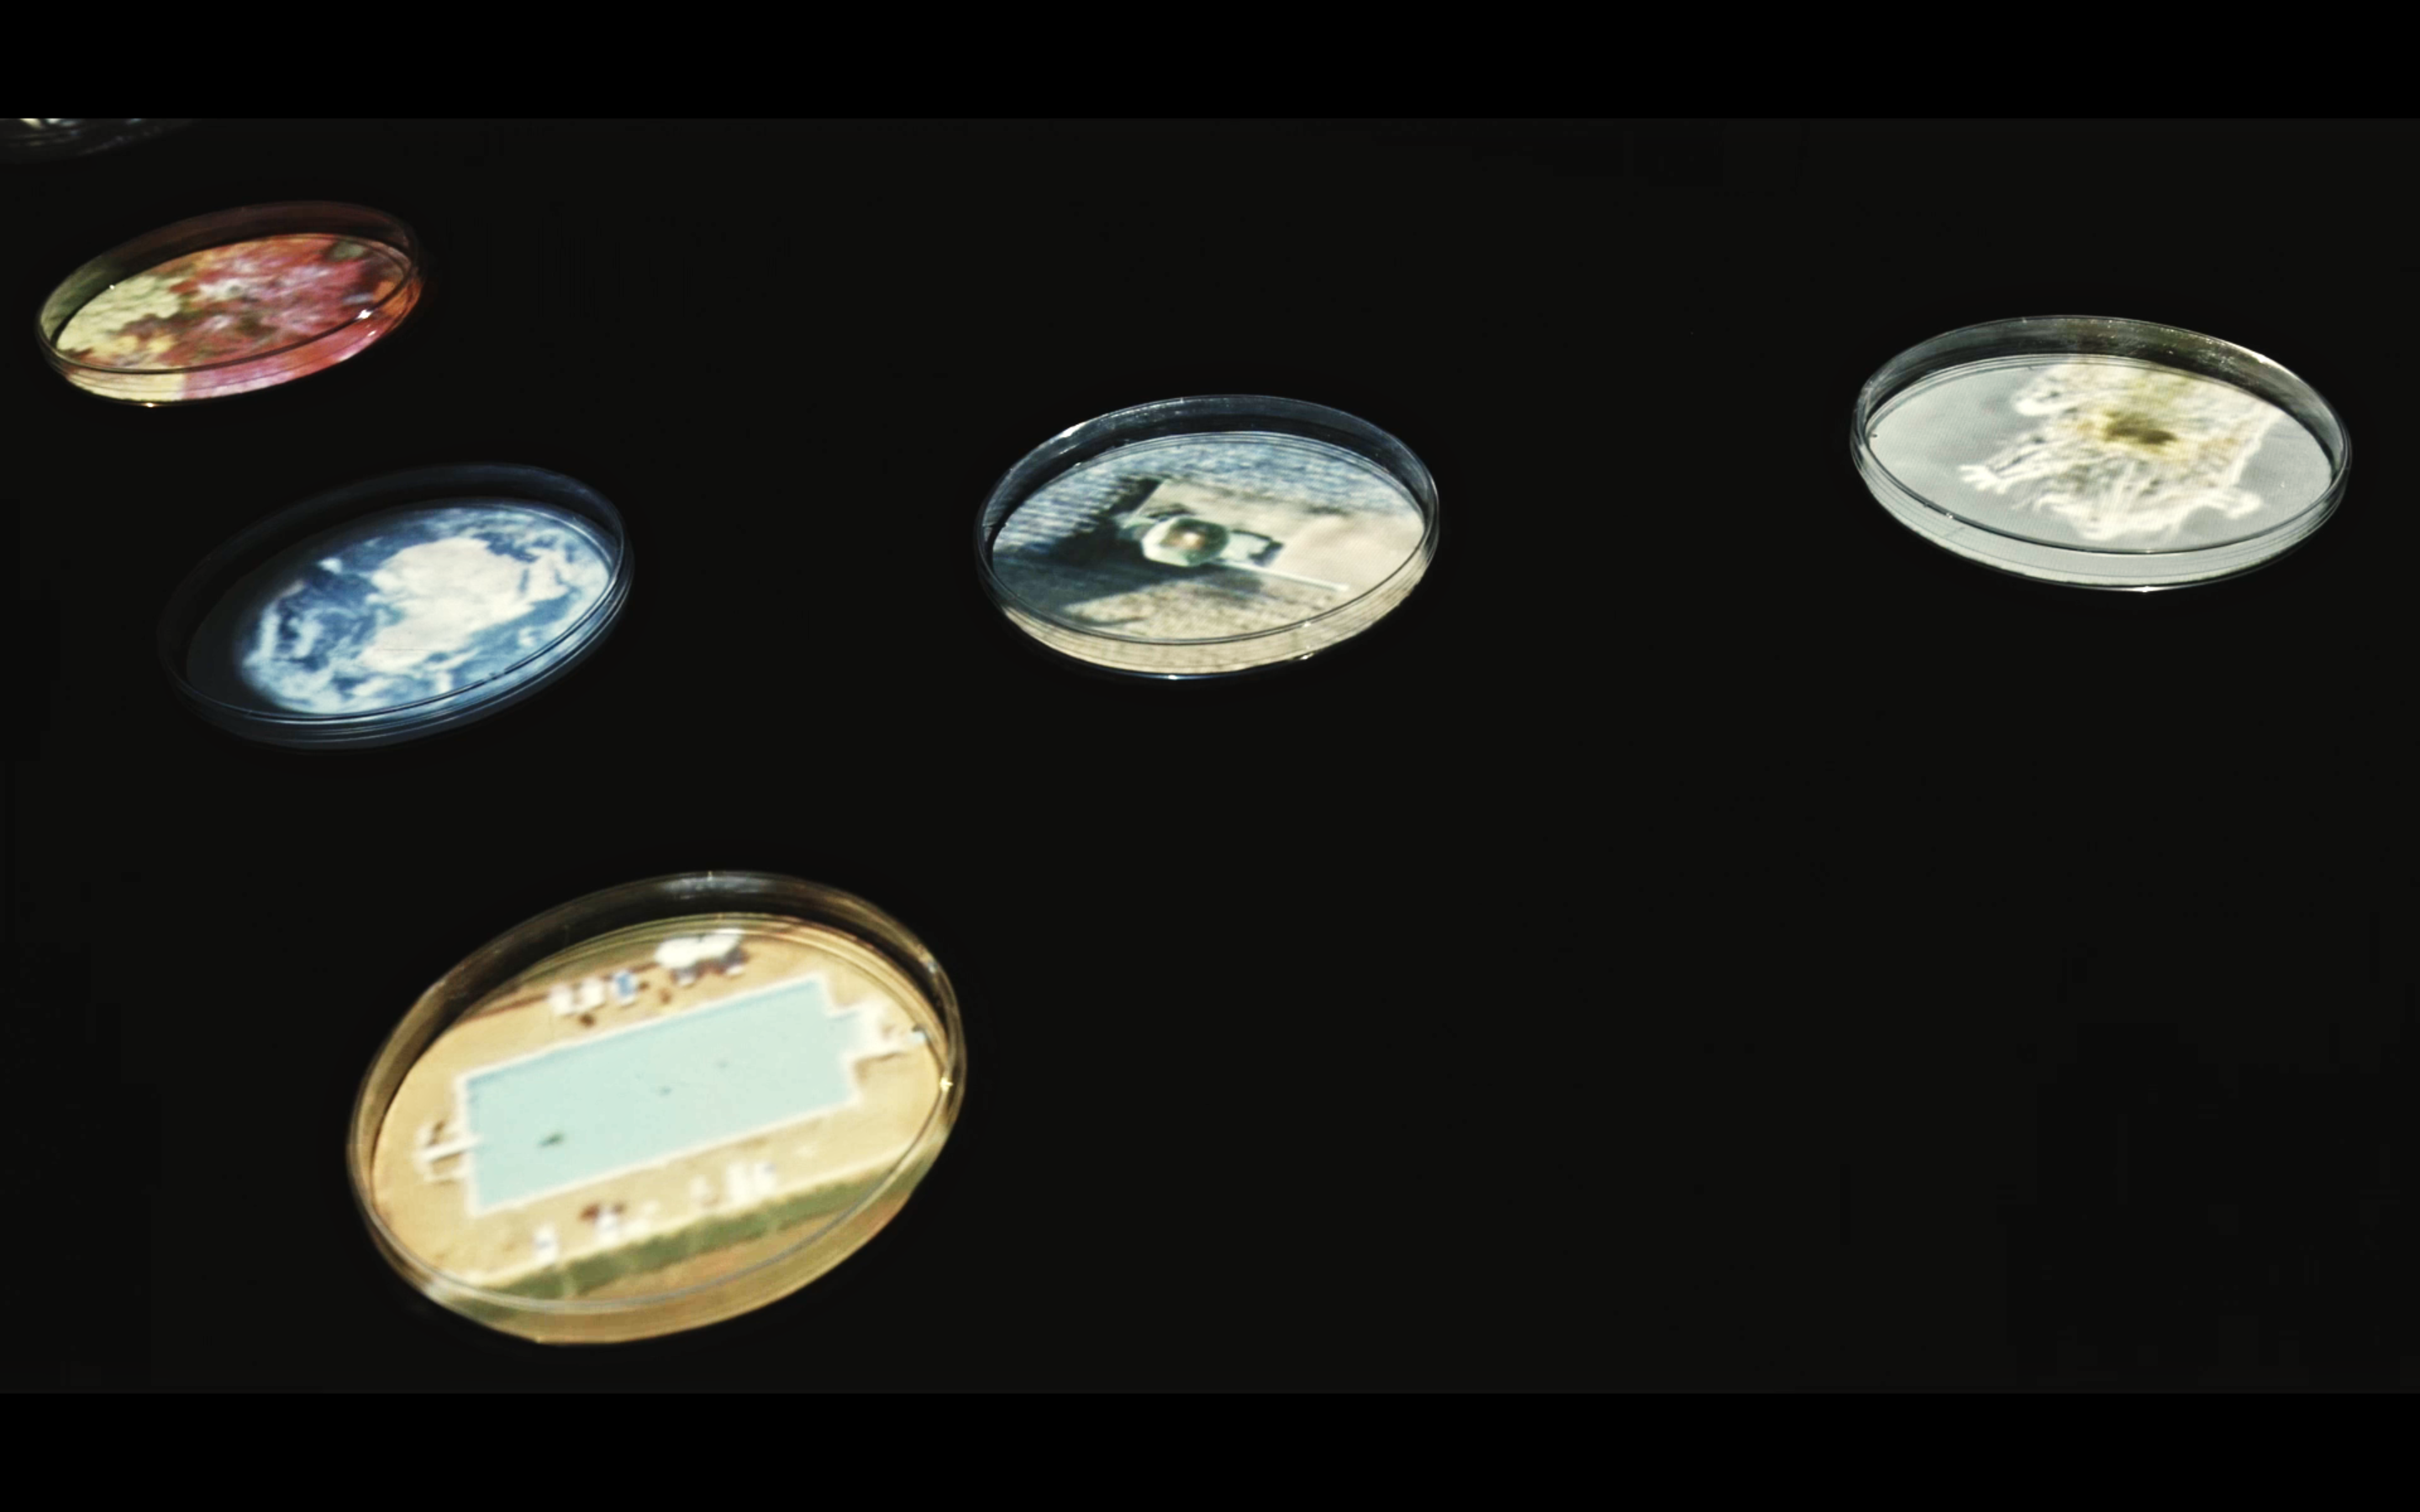

È temerità chiamar vano o superfluo
tutto quello dell'universo
che non serve per noi
Galileo Galilei
che non serve per noi
Galileo Galilei
m_CRO è un'installazione artistica realizzata assieme a scienziat* e diversi centri di ricerca del panorama scientifico della Regione Friuli Venezia Giulia, che invita ad interrogarci sull'antropocentrismo, ovvero la tendenza dell'uomo a considerarsi al centro del mondo in cui vive.
Siamo solo una piccola parte di qualcosa di più grande di noi.

Il microscopico e il macroscopico vengono parificati e posti allo stesso livello dimensionale: l'azione di osservare, unita alla sensazione di essere osservati, vuole destabilizzare la nostra visione egocentrica a favore di un'esistenza più ecocentrica.
Il progetto m_CRO utilizza la tecnica del videomapping con una proiezione zenitale su un tavolo: diverse immagini vengono proiettate all’interno di piastre Petri, contenitori discoidali disposti sul tavolo, utilizzati solitamente da scienziat* per far crescere colture di muffe e batteri.
In ambito scientifico, la piastra Petri è un contenitore di micromondi, osservabili al microscopio: un piccolo luogo dove l’azione di osservare è focalizzata a livello unidirezionale, cioè dall’uomo al microrganismo, dal MACRO al MICRO.
Questa unilateralità dello sguardo ci mette per forza di cose al centro del mondo in cui viviamo: da osservatori, ci assumiamo il ruolo di protagonisti indiscussi dell’ambiente in cui esistiamo.
Con questa installazione si intende innescare un corto circuito nel nostro modo di metterci in relazione con l’ambiente.

Al centro dell’installazione troviamo la Terra, intenta nella sua continua rotazione che ci porta dal giorno alla notte. Il ciclo circadiano guida il cambiamento delle altre proiezioni sui dischi adiacenti, sistemati in modo da comporre il simbolo dell’infinito.
I video proiettati all’interno dei dischi Petri rappresentano in parte protagonisti del mondo microscopico, come tardigradi, pollini, batteri, plancton...e in parte raffigurano noi esseri umani intenti a muoverci nel nostro mondo macroscopico, ma ripresi da un occhio osservatore esterno, quello della telecamera fissata su un drone.
Anche l’ambiente in cui l’uomo vive e si muove viene rimpicciolito e confinato all’interno di questi piccoli dischi adatti all’osservazione: litorali, boschi, fiumi e strade, città illuminate, edifici.
Possiamo quindi osservare alghe microscopiche nuotare all’interno del loro disco accanto ad esseri umani intenti a fare un bagno in piscina. E ancora, intricate ramificazioni di muffe assieme al foliage autunnale del Carso triestino.
Linee di luci solcano il cerchio delle Petri disegnando motivi geometrici, che difficilmente distinguiamo essere diatomee (piccole alghe unicellulari) o città illuminate di notte riprese dall’alto.
Ad aggiungersi alle proiezioni di micro e macro mondi anche delle vere colture batteriche poste sempre all’interno di piastre Petri, e uno specchio rotondo a completare il simbolo dell’infinito, tramite il quale è possibile inserire la propria identità all’interno dell’installazione un ulteriore aiuto per destabilizzare la propria visione egocentrica del mondo.
Esposizioni
Scienza e Virgola Festival - Trieste 2022
Jazz Matec - Udine 2022
Fronda Urbana Festival - Udine 2022
Cross Border Tribute to a Vision Film Festival - Nova Gorica (SLO) 2022
Un progetto di Francesco Scarel
musica di Andrea Gulli
I video e le immagini raccolte per questa installazione provengono da diverse fonti. Alcune, riguardanti plancton, sono state da me registrate all’Istituto Nazionale di Oceanografia e di Geofisica Sperimentale durante una residenza artistica di tre giorni, assieme all’artista Stefania Rota e ad Alfred Beran, scienziato ricercatore in sede.
Le colture batteriche e muffe reali sono state incubate in SISSA - Scuola Internazionale Superiore di Studi Avanzati, in particolare grazie a Sara Finaurini post doc al Computational Genomics Laboratory del prof. Remo Sanges e Christina Vlachouli dello staff tecnico di Neurobiology & Functional and Structural Genomics
L’International Centre for Genetic Engineering and Biotechnology (ICGEB) e il laboratorio della prof. Zacchigna ha gentilmente fornito materiale video riguardante la loro ricerca sui cardiomiociti.
Sara Brandoli, studentessa nel Laboratorio di Zoologia Evolutiva di Unimore - Università degli Studi di Modena e Reggio Emilia ha invece realizzato e gentilmente fornito i video dei tardigradi.